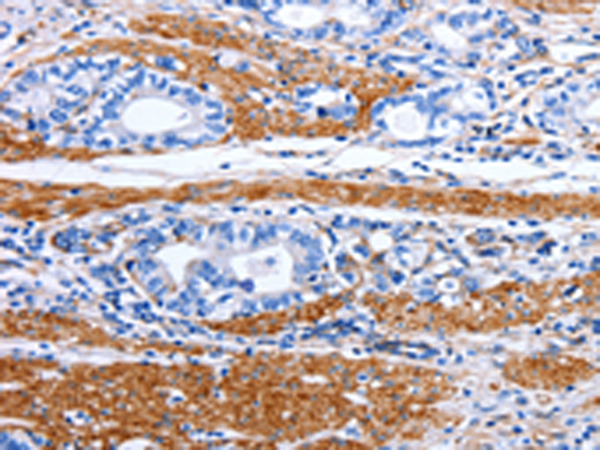
一抗

中文名稱: 兔抗PRKAB1多克隆抗體
英文名稱: Anti-PRKAB1 rabbit polyclonal antibody
別 名: AMPK, HAMPKb
相關(guān)類別: 一抗
儲 存: 冷凍(-20℃)
宿 主: Rabbit
抗 原: PRKAB1
反應(yīng)種屬: Human, Mouse, Rat
標(biāo) 記 物: Unconjugate
克隆類型: rabbit polyclonal
技術(shù)規(guī)格
|
Background: |
The protein encoded by this gene is a regulatory subunit of the AMP-activated protein kinase (AMPK). AMPK is a heterotrimer consisting of an alpha catalytic subunit, and non-catalytic beta and gamma subunits. AMPK is an important energy-sensing enzyme that monitors cellular energy status. In response to cellular metabolic stresses, AMPK is activated, and thus phosphorylates and inactivates acetyl-CoA carboxylase (ACC) and beta-hydroxy beta-methylglutaryl-CoA reductase (HMGCR), key enzymes involved in regulating de novo biosynthesis of fatty acid and cholesterol. This subunit may be a positive regulator of AMPK activity. The myristoylation and phosphorylation of this subunit have been shown to affect the enzyme activity and cellular localization of AMPK. This subunit may also serve as an adaptor molecule mediating the association of the AMPK complex. |
|
Applications: |
ELISA, IHC |
|
Name of antibody: |
PRKAB1 |
|
Immunogen: |
Synthetic peptide of human PRKAB1 |
|
Full name: |
protein kinase, AMP-activated, beta 1 non-catalytic subunit |
|
Synonyms: |
AMPK, HAMPKb |
|
SwissProt: |
Q9Y478 |
|
ELISA Recommended dilution: |
1000-2000 |
|
IHC positive control: |
Human stomach cancer and Human liver cancer |
|
IHC Recommend dilution: |
10-50 |

 購物車
購物車 幫助
幫助
 021-54845833/15800441009
021-54845833/15800441009